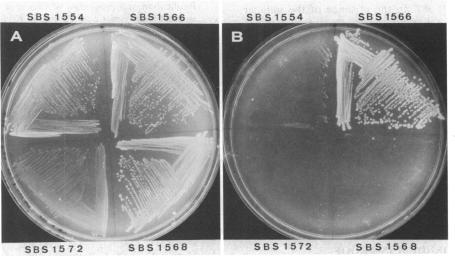
https://cdn.ncbi.nlm.nih.gov/pmc/blobs/685d/210078/730d12a1f053/jbacter00172-0615-a.jpg

Mapping of the Escherichia coli acid glucose-1-phosphatase gene agp and analysis of its expression in vivo by use of an agp-phoA protein fusion.
作者信息
Pradel E, Boquet P L
机构信息
Département de Biologie, CEN Saclay, Gif-sur-Yvette, France.
出版信息
J Bacteriol. 1989 Jun;171(6):3511-7. doi: 10.1128/jb.171.6.3511-3517.1989.
The agp gene of Escherichia coli encodes an acid glucose-1-phosphatase, one of the numerous phosphatases optimally active between pH 4 and 6 found in the periplasmic space of this bacterium. An agp-phoA protein fusion linked to a gene conferring kanamycin resistance was inserted into the chromosome in place of agp by homologous recombination and was mapped to minute 22.6. Because the activity of glucose-1-phosphatase cannot be measured accurately in whole cells, the alkaline phosphatase activity of the agp-phoA hybrid protein was used to monitor the expression of the chromosomal agp gene. The expression of agp was subject to catabolite repression but was unaffected by the concentration of inorganic phosphate in the growth medium. The product of the agp gene was required for growth on glucose-1-phosphate as the sole carbon source, a function for which alkaline phosphatase or other acid phosphatases cannot substitute.